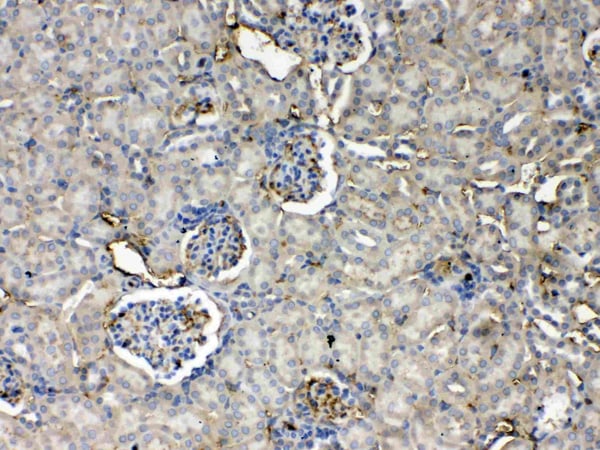

Filters
Clonality
Type
Reactivity
Gene Name
Isotype
Host
Application
Clone
12 results for " Other epigenetics" - showing 1-12
APOA1, Antibody (Cat# AAA17952)
ZNF595, Polyclonal Antibody (Cat# AAA17999)
Predicted: Rat, Mouse.
Not yet tested in other species.
TriMethyl-Histone H3-K64, Polyclonal Antibody (Cat# AAA28312)
Acetyl-Histone H3-K4, Polyclonal Antibody (Cat# AAA28322)
CD105, Polyclonal Antibody (Cat# AAA19165)
No cross reactivity with other proteins.
MED18, Polyclonal Antibody (Cat# AAA19179)
No cross reactivity with other proteins.
MED9, Polyclonal Antibody (Cat# AAA19180)
No cross reactivity with other proteins.
ADA/Adenosine Deaminase, Polyclonal Antibody (Cat# AAA19140)
No cross reactivity with other proteins.
MED4, Polyclonal Antibody (Cat# AAA19178)
No cross reactivity with other proteins.
Thrombopoietin, Polyclonal Antibody (Cat# AAA19166)
No cross reactivity with other proteins
MED15/Pcqap, Polyclonal Antibody (Cat# AAA19169)
No cross reactivity with other proteins.
Ran, Polyclonal Antibody (Cat# AAA19131)
No cross reactivity with other proteins.